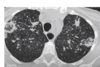
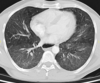

Cisto hidátido pulmonar
Membranas na porção líquida do cisto.

Aumento do tronco da artéria pulmonar
Estenose congenita da valva pulmonar.

Mesotelioma
80 Mulher, Tosse

Consolidação com cavitação em lobo superior direito
Adenocarcinoma

Consolidação em lobo superior direito com áreas de cavitação
Padrão de micronódulos centrolobulares com árvore em brotamento
TB pós primária.
RN a termo.

Cardiomegalia massiva em um neonato com pulmão normal (sem edema alveolar ou intersticial, sem derrame pleural)
Cardiomiopatia neonatal.

COVID-19 Pneumonia.

Empiema pleural

Edema pulmonar cardiogênico

Lipoma do músculo intercostal
2 anos, masculino

Cisto de duplicação esofágico
Predleção por meninos; diagnosticados na infância
Em geral assintomáticos; podem provocar estridor
Mais comuns no esôfago distal; geralmente não comunicam com a luz do esôfago;
TC: Cisto com densidade de líquido, margens bem definidas que podem realçar com contraste; podem complicar com hemorragia, infecção: nível liquido, espessamento parietal.

Cisto de duplicação esofágico
Predleção por meninos; diagnosticados na infância
Em geral assintomáticos; podem provocar estridor
Mais comuns no esôfago distal; geralmente não comunicam com a luz do esôfago;
TC: Cisto com densidade de líquido, margens bem definidas que podem realçar com contraste; podem complicar com hemorragia, infecção: nível liquido, espessamento parietal.

Cisto de duplicação esofágico
Predleção por meninos; diagnosticados na infância
Em geral assintomáticos; podem provocar estridor
Mais comuns no esôfago distal; geralmente não comunicam com a luz do esôfago;
TC: Cisto com densidade de líquido, margens bem definidas que podem realçar com contraste; podem complicar com hemorragia, infecção: nível liquido, espessamento parietal.
70 anos, masculino
Disfagia.

Leiomioma do esôfago
Neoplasias benignas do esôfago são raras (<1% dos tumores do esôfago)
TC: Massa intramural, bem definida, circunscrita, arredondada; densidade de partes moles; calcificação é quase patognomônico; realce difuso discreto / moderado pelo contraste.
Tumores pequenos < 5 cm geralmente são assintomáticos; tumores maiores podem causar disfagia, obstrução, tosse e sangramento.
Disfagia

Leiomioma do esôfago
Neoplasias benignas do esôfago são raras (<1% dos tumores do esôfago)
TC: Massa intramural, bem definida, circunscrita, arredondada; densidade de partes moles; calcificação é quase patognomônico; realce difuso discreto / moderado pelo contraste.
Tumores pequenos < 5 cm geralmente são assintomáticos; tumores maiores podem causar disfagia, obstrução, tosse e sangramento.

Leiomioma do esôfago
Neoplasias benignas do esôfago são raras (<1% dos tumores do esôfago)
TC: Massa intramural, bem definida, circunscrita, arredondada; densidade de partes moles; calcificação é quase patognomônico; realce difuso discreto / moderado pelo contraste.
Tumores pequenos < 5 cm geralmente são assintomáticos; tumores maiores podem causar disfagia, obstrução, tosse e sangramento.

Leiomioma do esôfago
Neoplasias benignas do esôfago são raras (<1% dos tumores do esôfago)
TC: Massa intramural, bem definida, circunscrita, arredondada; densidade de partes moles; calcificação é quase patognomônico; realce difuso discreto / moderado pelo contraste.
Tumores pequenos < 5 cm geralmente são assintomáticos; tumores maiores podem causar disfagia, obstrução, tosse e sangramento.

Pólipo fibrovascular do esôfago;
Tumor benigno do esôfago (2º benigno mais comum, só perde para o leiomioma)
Tumor intraluminal, pedunculado; geralmente no terço superior do esôfago;
CT: Lesão de densidade de partes moles, pedunculada no terço proximal do esôfago; pode conter gordura em seu interior (hipodenso).

Pólipo fibrovascular do esôfago;
Tumor benigno do esôfago (2º benigno mais comum, só perde para o leiomioma)
Tumor intraluminal, pedunculado; geralmente no terço superior do esôfago;
CT: Lesão de densidade de partes moles, pedunculada no terço proximal do esôfago; pode conter gordura em seu interior (hipodenso).

Lipomatose mediastinal
Deposição de gordura no mediastino; causa benigna de alargamento mediastinal.
Mais comum no mediastino superior;
Causa: Uso de corticóide, Sindrome de cushing, obesidade;

Lipomatose mediastinal
Deposição de gordura no mediastino; causa benigna de alargamento mediastinal.
Mais comum no mediastino superior;
Causa: Uso de corticóide, Sindrome de cushing, obesidade;
80 anos; feminino.

Carcinoma esofágico
CT: Espessamento circunferencial ou excêntrico da parede > 5 mm; densificação da gordura periesofágica; deposição de líquido e debris no esôfago proximal dilatado;
Espinocelular é mais comum nos terços proximal e médio e o Adenocarcinoma no terço distal.

Carcinoma esofágico
CT: Espessamento circunferencial ou excêntrico da parede > 5 mm; densificação da gordura periesofágica; deposição de líquido e debris no esôfago proximal dilatado;
Espinocelular é mais comum nos terços proximal e médio e o Adenocarcinoma no terço distal.
Mulher, refluxo gastroesofágico crônico.

Carcinoma esofágico
CT: Espessamento circunferencial ou excêntrico da parede > 5 mm; densificação da gordura periesofágica; deposição de líquido e debris no esôfago proximal dilatado;
Espinocelular é mais comum nos terços proximal e médio e o Adenocarcinoma no terço distal.